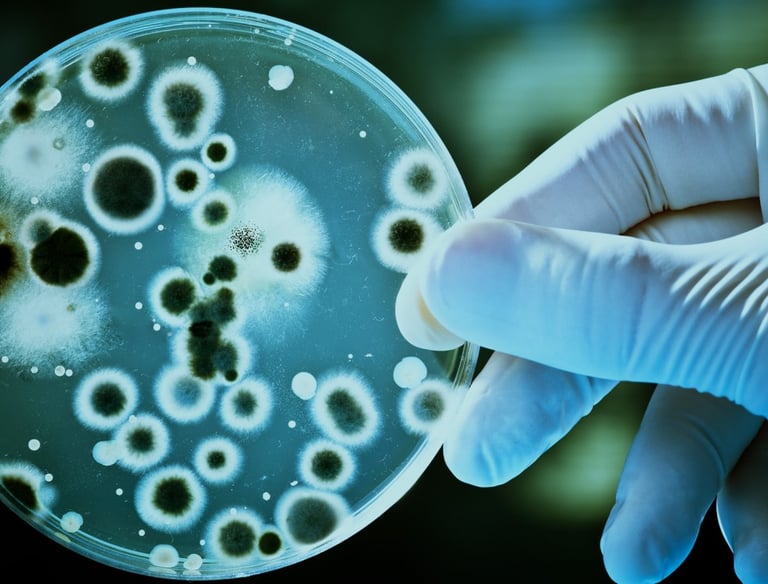
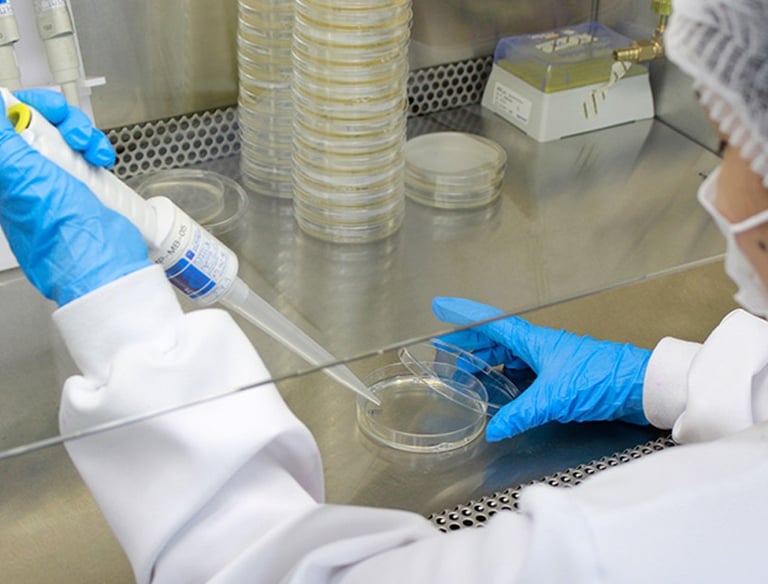

Serviços - Grupo Acqualimp
O Grupo Acqualimp é composto por duas empresas especializadas em oferecer soluções para ambientes mais seguros, saudáveis e bem conservados: AMB Laboratórios e Dedetizadora Acqualimp. Conheça nossos serviços.

Realizamos análises laboratoriais precisas para avaliar a qualidade de diferentes amostras, garantindo segurança e conformidade com normas técnicas. Nossos serviços são fundamentais para empresas que buscam cumprir regulamentações e oferecer ambientes mais seguros.




Monitoramos e analisamos a qualidade do ar em ambientes climatizados, identificando contaminantes como mofo, bactérias e partículas nocivas. Ideal para empresas, hospitais e escolas que buscam ambientes saudáveis e produtivos.
Oferecemos análises especializadas para detectar a presença da bactéria Legionella, causadora da Doença dos Legionários, em sistemas de água. Este serviço é essencial para edifícios comerciais e industriais.

Avaliamos a potabilidade da água, verificando se ela está adequada para consumo humano, atendendo às exigências das autoridades sanitárias.
Serviços Eficazes
Dedetização, limpeza de dutos e análise de ar e água.


Eliminamos pragas urbanas como baratas, formigas, ratos e cupins com métodos seguros e eficientes, protegendo sua saúde e seu patrimônio.




Realizamos a higienização completa de caixas d'água e cisternas para garantir que o abastecimento seja seguro e livre de contaminações.
Higienizamos coifas industriais e residenciais, removendo gordura acumulada e resíduos que podem causar incêndios ou comprometer a qualidade do ar. De acordo com a legislação vigente.


Realizamos a limpeza e manutenção de dutos de ventilação e exaustão, garantindo um sistema eficiente e um ar mais puro.
Por que escolher o Grupo Acqualimp?
Nossa equipe é composta por profissionais qualificados, utilizando tecnologia avançada para entregar resultados que superam expectativas. Trabalhamos com foco na saúde, segurança e bem-estar de nossos clientes, sempre em conformidade com as normas regulatórias.
Entre em contato conosco para conhecer melhor nossas soluções e fazer um orçamento!
Conheça os benefícios de cada serviço
Acqualimp & AMB: Qualidade garantida
Análises de Laboratório
Benefícios:
Garantia de resultados confiáveis.
Adequação a padrões regulatórios.
Suporte para a saúde pública e ambiental.
Qualidade do Ar Interior
Benefícios:
Redução de problemas respiratórios.
Melhoria no bem-estar e produtividade.
Conformidade com normas vigentes.
Legionella
Benefícios:
Prevenção de surtos de doenças graves.
Cumprimento de regulamentações sanitárias.
Preservação da saúde pública.
Potabilidade da Água
Benefícios:
Segurança no consumo de água.
Prevenção de doenças de origem hídrica.
Conformidade com padrões de saúde e segurança.
Dedetização
Benefícios:
Ambiente livre de pragas.
Prevenção de doenças.
Preservação de imóveis e estruturas.
Limpeza de Caixas de Água
Benefícios:
Água mais limpa e saudável.
Prevenção de doenças hídricas.
Conformidade com normas sanitárias.
Limpeza de Coifas
Benefícios:
Prevenção de riscos de incêndio.
Melhor funcionamento do sistema de exaustão.
Ambiente mais seguro e limpo.
Limpeza de Dutos
Benefícios:
Redução de contaminação do ar.
Melhoria na eficiência dos sistemas.
Prevenção de problemas respiratórios.
Limpeza e Troca de Refil de Filtro
Benefícios:
Remoção dos resíduos contaminantes.
Redução de odores e sabores desagradáveis.
Melhoria na pressão e fluxo de água.
Remoção segura do refil antigo.
Links Rápidos
Contato
Orçamento
© 2024. All rights reserved. criado por carlamunizmktdigital
Conecte-se conosco
Política de privacidade




